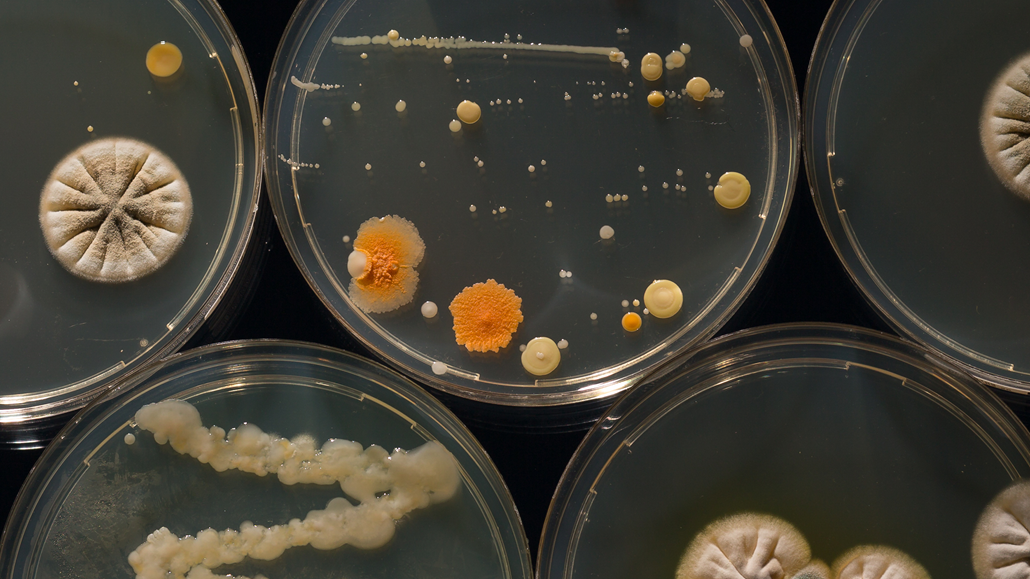
氧气感应

订阅我们的博客
从我们的团队得到更新,因为我们分享应用笔记,客户射灯,教育工具,光谱学如何做的,等等。

了解最近加强海洋洞察光学氧传感器,包括工艺环境中简化探头,扩大了可行性亚博最新网站多少测试选项,并为NeoFox氧气系统的新软件。
由于在传感器材料和光电子的进步,海洋洞察提供新的光学氧传感器用于生物医学和生命科学应用,环境监测,食品和饮料加工,制药和亚博最新网站多少更多。操作的原理是在陷阱被施加到纤维或粘合剂膜的尖端例如贴片的溶胶 - 凝胶基质的氧敏感的荧光团。
与电化学感测技术,例如电传感器相比,光学氧传感器可以在小和可定制的形状因子来制成,允许非侵入式测量,并且不消耗样品。